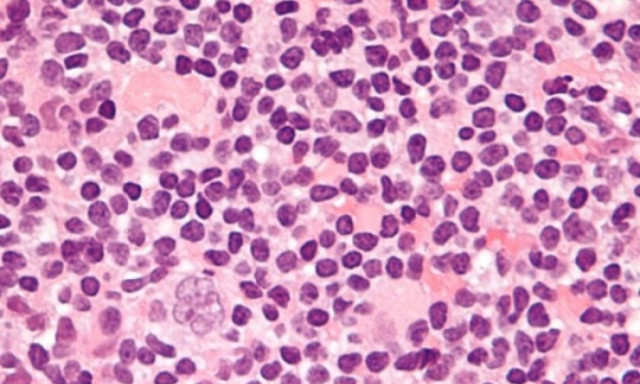
ΑγκαλιάΖΩ - Roche: Εκστρατεία ενημέρωσης για το λέμφωμα

ΛΕΜΦΩΜΑ

Μάχη με σπάνια ασθένεια για μέλος του δημοφιλούς συγκροτήματος «The Cure»
ΚΟΣΜΟΣ
·
01.09.2024 - 18:37
Ο 68χρονος μουσικός είπε στους θαυμαστές του πως διαγνώστηκε με μια «πολύ σπάνια και επιθετική μορφή» λεμφώματος

Γιώργος Ζαγκλιβέρης: «Το κενό που αφήνει πίσω είναι πολύ μεγάλο» - Συγκινούν οι γονείς του
ΕΛΛΑΔΑ
·
11.03.2024 - 13:24
«Είχε πολλά όνειρα σαν παιδί», είπε ο πατέρας του 30χρονου ποδοσφαιριστή που έφυγε από τη ζωή

Αθήνα Αφαλίδου: «Ο άντρας μου διαγνώστηκε με λέμφωμα Non-Hodgkin στο 4ο στάδιο»
LIFESTYLE
·
08.02.2024 - 08:53
Σοκάρει η αποκάλυψη της Αθηνάς Αφαλίδου για το πρόβλημα υγείας του συζύγου της - Διαγνώστηκε με καρκίνο στο αίμα.

Σοκ για Λάινερ - Διαγνώστηκε με καρκίνο στους λεμφαδένες ο άσος της Γκλάντμπαχ
ΠΟΔΟΣΦΑΙΡΟ
·
27.07.2023 - 14:10
Η Γκλάντμπαχ έκανε γνωστό πως ο Στέφαν Λάινερ διαγνώστηκε με καρκίνο στους λεμφαδένες, με τον 32χρονο να μένει εκτός δράσης για αρκετούς μήνες, ώστε να…

Βρετανία: 20χρονη είχε φαγούρα που αποδείχθηκε ότι ήταν ένδειξη για καρκίνο (photos+vid)
ΚΟΣΜΟΣ
·
18.02.2022 - 12:51
Μια make-up artist αποκάλυψε ότι η φαγούρα στο δέρμα που νόμιζε ότι προκλήθηκε από την αλλαγή της σκόνης πλυσίματος, ήταν στην πραγματικότητα καρκίνος.

Η CAR-T θεραπεία της Novartis εμφανίζει συνεπή αποτελεσματικότητα και ασφάλεια
ΦΑΡΜΑΚΟ
·
14.01.2020 - 18:23
Στους ασθενείς των ΗΠΑ, όταν χρησιμοποιείται στην καθημερινή κλινική πράξη - Αποτελέσματα από δύο αναλύσεις πραγματικής κλινικής εμπειρίας

Σημαντικές εξελίξεις στη θεραπεία του Πολλαπλού Μυελώματος και του Λεμφώματος Hodgkin’s
ΦΑΡΜΑΚΟ
·
07.11.2018 - 14:35
Το 29ο Πανελλήνιο Αιματολογικό Συνέδριο πραγματοποιήθηκε από την 1η έως τις 4 Νοεμβρίου 2018, στη Θεσσαλονίκη. Στο πλαίσιο του συνεδρίου, η εταιρεία Takeda Hellas διοργάνωσε…

Η Ελλάδα έχει τα περισσότερα νέα περιστατικά λεμφώματος Hodgkin στον κόσμο
ΥΓΕΙΑ
·
04.06.2018 - 11:59
H χώρα με τις περισσότερες νέες διαγνώσεις του λεμφώματος Hodgkin, ενός τύπου καρκίνου των λεμφοκυττάρων, είναι η Ελλάδα, σύμφωνα με νέα μελέτη.
ΑγκαλιάΖΩ - Roche: Εκστρατεία ενημέρωσης για το λέμφωμα
ΦΑΡΜΑΚΟ
·
15.09.2015 - 18:49
Με κεντρικό σύνθημα «Έχω Λέμφωμα και ΣυνεχίΖω να Ζω τη Ζωή μου», ο Όμιλος Εθελοντών Κατά του Καρκίνου-ΑγκαλιάΖΩ, με τη χορηγία της Roche Hellas και…

Μια συγκλονιστική ιστορία αγάπης που πρέπει να διαβάσετε...
WHAT THE FACT
·
11.11.2012 - 16:53
Γιατί πράγματι υπάρχει πραγματική αγάπη...






